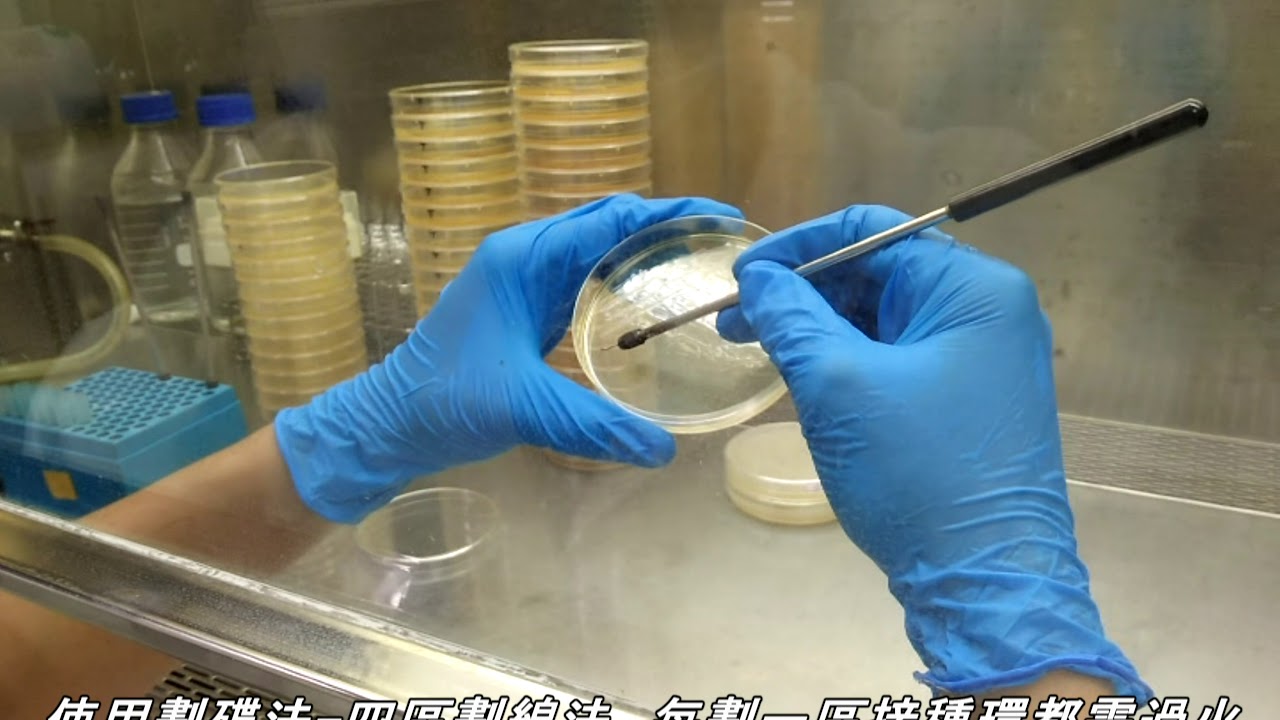

目錄
技術分析中四區劃線法失效的常見原因與市場心理學解析
點擊上方四區劃線圖了解技術分析方法的基本原理和失效情況
📊 四區劃線法失敗原因
📈 四區劃線圖
買進
觀望
加碼
賣出
❌ 失敗原因分析
四區劃線法失敗原因探討:實驗室常見問題分析
說到微生物實驗操作,新手最常卡關的就是四區劃線法老是出包。明明照著SOP一步步來,怎麼就是搞不出完美的獨立菌落?其實關鍵藏在魔鬼細節裡,今天就來分享實驗室老鳥才知道的實戰技巧。
首先要留意的就是接種環的加熱程度。燒過頭會讓菌種直接GG,溫度不夠又沾不起來。小撇步是在火焰外圍加熱到稍微泛紅就OK,放涼時可以輕觸培養基邊緣確認溫度。再來施力拿捏不當也很母湯,下手太重會刮傷培養基,太輕又帶不動菌體。建議用手腕整體發力,保持每一區的力道都要差不多。
|
常見錯誤類型 |
具體表現 |
改善建議 |
|---|---|---|
|
接種環操作不當 |
菌量過多/過少 |
練習沾取1-2環菌液 |
|
劃線角度錯誤 |
線條重疊或間距過大 |
保持30-45度傾斜 |
|
培養基問題 |
表面過濕或乾裂 |
倒板後靜置30分鐘 |
再來很多人忽略培養基狀態。太濕的話菌會隨水膜擴散,太乾又不利生長。最佳狀態是用手指輕觸不黏手,倒板後要等冷凝水蒸發。還有個隱形殺手是環境汙染,實驗前沒用酒精消毒桌面,或是說話時飛沫噴到平板,這些都會讓雜菌長得比目標菌還歡。
最後要提醒菌種特性差異。像鏈球菌這種嬌貴的菌,劃線時要特別溫柔;而枯草桿菌這種強壯的,就算劃得稍微粗暴點也沒關係。建議新手先從大腸桿菌練習,等手感穩定了再挑戰難搞的菌種。記得每次劃完都要觀察菌落分布,慢慢調整自己的手法。

為什麼四區劃線法會失敗?常見原因大公開!這幾年不少公司在導入這個管理方法時都踢到鐵板,今天就來跟大家聊聊那些藏在細節裡的魔鬼,讓你的團隊避免重蹈覆轍。
首先最常見的問題就是「區域界線模糊」,很多主管以為劃四個框框就完事了,結果各區員工整天在吵「這案子到底歸誰管」。像去年某科技公司就發生業務和客服互推客戶投訴,最後客戶氣到直接解約。建議劃分時要明確寫出各區的「權責清單」,最好連交接流程都白紙黑字列出來。
第二個地雷是「KPI設定太理想化」,表格整理幾個實際案例給大家參考:
|
公司類型 |
問題KPI設定 |
實際狀況 |
|---|---|---|
|
零售業 |
要求倉儲區兼顧揀貨速度與盤點準確率 |
員工為達標狂衝速度導致庫存數字全亂 |
|
製造業 |
生產線需同時達成良率與產量目標 |
幹部為求良率偷偷降速被總公司抓包 |
|
電商 |
客服部門要兼顧回應速度與滿意度 |
客服為快速結案敷衍了事引來負評 |
![實驗] 微生物的接種與環境中的微生物 實驗] 微生物的接種與環境中的微生物](https://blogger.googleusercontent.com/img/b/R29vZ2xl/AVvXsEi-FnJaY83i2FGi9IxCXnry-Az4pnT62iS_TwhCosY1KS65xr01IxZ9KsdmCIYy5E7oiur0o3b0mzKdUzYIg6IE4YHTYJr627dzfJ78vHu3VvyErPNY_dk_EmWFdg7HY4EgBONrW8FflX8U/w1200-h630-p-k-no-nu/%25E6%259C%25AA%25E5%2591%25BD%25E5%2590%258D.png)
新手必看!四區劃線失敗的5個關鍵時刻
各位剛接觸劃線技巧的朋友們,這篇絕對要收藏起來!很多人在練習時都會踩到一樣的雷,導致劃出來的線歪歪扭扭。今天就來分享那些最容易搞砸的瞬間,幫大家避開這些坑!
首先就是工具用錯的狀況。不少人覺得隨便抓支原子筆就能畫,結果線條像蚯蚓爬過一樣。其實不同材質要搭配不同筆種,像磁磚這種光滑面要用油性麥克筆,木頭表面反而用粉筆效果更好。工具選不對,後面再怎麼努力都是做白工。
再來是忘記清潔這個致命傷。台灣天氣潮濕,牆面跟地板常常卡一堆灰塵跟污垢。我之前貪快沒擦就直接畫,結果線條斷斷續續超醜。建議先用酒精濕巾或乾抹布把要畫的地方擦乾淨,效果真的差超多!
|
失敗時刻 |
常見問題 |
改善方法 |
|---|---|---|
|
工具選擇 |
筆種不適合材質 |
先測試不同筆種效果 |
|
表面清潔 |
灰塵影響附著力 |
劃線前用酒精擦拭 |
|
施力不均 |
線條粗細不一 |
保持固定角度和力道 |
再來是施力不均這個大魔王。新手常會因為緊張或姿勢不對,劃到一半手抖導致線條變形。建議可以找個支撐點靠著手肘,或是先用鉛筆打草稿。我有個朋友更聰明,他會先用紙膠帶貼出輔助線,這樣怎麼劃都不會歪。
第四個容易失敗的時刻是環境光線不足。台灣很多人家裡燈光都偏黃,在這種光線下劃線很容易看錯位置。特別是晚上加班趕工時特別容易發生,建議一定要開白光燈或用手電筒輔助照明。
最後就是急著收工的時候。很多人劃完線就馬上碰觸或上其他材料,結果還沒乾透的線條就這樣糊掉了。特別是水性筆在潮濕環境下要等更久,建議至少等15分鐘再進行下一步驟。

實驗室老手都遇過的四區劃線NG狀況,這些雷你踩過幾個?
在實驗室打滾多年的朋友一定懂,四區劃線看起來簡單,但手滑起來真的會讓人想撞培養皿啊!今天就來聊聊那些連資深學長姐都可能翻車的常見狀況,順便分享一些實用小技巧,讓你下次劃線時不再手忙腳亂。
首先最常見的就是劃線力道控製不當,新手常常太緊張導致劃到瓊脂都刮起來,或是太輕根本沒留下菌落。老手建議用鉛筆在紙上練習幾次,找到那種「剛好劃破表面」的手感。另外酒精燈使用時機也很重要,記得要在火焰旁快速冷卻接種環,但千萬別傻傻把整個環燒到通紅啊!
|
NG狀況 |
發生原因 |
補救方法 |
|---|---|---|
|
線條重疊交叉 |
手抖或忘記轉動培養皿角度 |
用標籤貼標記起始點 |
|
第四區沒長出單一菌落 |
接種環帶菌量不足 |
第三區多停留2秒增加菌量 |
|
劃線區域分配不均 |
沒預先規劃分區比例 |
先用油性筆在皿底畫參考線 |
|
汙染雜菌 |
接種環冷卻不完全 |
等待5秒再碰觸菌落 |
再來就是很多人會忽略的培養皿溫度問題,這真的是新手常犯的錯誤之一。剛從4°C冰箱拿出來的培養基表面會因為溫差而凝結大量水珠,這些冷凝水會讓接種環上的菌液被稀釋,嚴重影響後續菌落分離的效果。建議可以採取以下兩種做法:第一是提前30-40分鐘將培養皿從冰箱取出,放在無菌操作台內回溫至室溫(約25°C);第二種更快速的方法是使用經過高壓滅菌的無菌紙巾,輕輕按壓培養基表面吸除水氣,但要注意動作一定要輕柔,避免破壞瓊脂表面。
另外老鳥們都知道要預留邊緣1cm不劃線這個黃金法則,這可不是隨便說說的!因為在開蓋觀察或移動培養皿時,手指很容易不小心碰到邊緣區域。如果這個區域有劃線,就可能引入環境中的雜菌造成污染。更專業的做法是:先用無菌筆在皿底標記1cm邊界線,劃線時嚴格控制在界線內。有些實驗室甚至會特別訓練新手這個細節,因為真的會影響整個實驗的成敗啊!
最後要提醒大家,不同菌種適合的劃線力道其實差異很大,這需要經驗累積。像大腸桿菌(E. coli)這類革蘭氏陰性菌比較強壯,劃線時可以施加適當力道(約100-150g壓力),讓接種環稍微陷入瓊脂表面也沒關係。但遇到像乳酸菌(Lactobacillus)這類嬌貴的革蘭氏陽性菌,就要像畫水彩畫一樣輕柔(50g以下壓力),最好只用接種環尖端輕輕掠過表面。每次換新菌種時,建議先在廢棄培養皿上練習幾次,感受最適合的力道。實驗室前輩常說:「劃線手感就像煮飯的火候,每種菌都有自己的脾氣!」真的不能以為同一招可以適用所有菌種喔~
四區劃線法失敗原因
在做微生物實驗時,很多新手常遇到四區劃線法失敗原因,明明照著步驟做卻總是得不到理想結果。其實這項技術看似簡單,卻藏著許多魔鬼細節,從接種環溫度到劃線角度都會影響最終菌落分離效果。今天就來幫大家整理最常見的失誤點,讓你下次實驗能順利獲得漂亮的單一菌落!
核心要點
-
接種環溫度沒控制好
太燙會直接把菌燙死,太涼又沾不起菌液。建議先在無菌區放涼3-5秒,碰觸培養基表面測試溫度,聽到輕微”嘶”聲就是最佳狀態。 -
劃線力道不均勻
第一區要稍微用力確保取到菌,但後面幾區必須「輕如羽毛」!很多人劃到第四區時手勁還跟第一區一樣,結果菌落全都擠在一起分不開。 -
培養基表面太濕
冷凝水沒擦乾就直接劃線,菌液會被水分帶著亂跑。實驗前記得把平板倒置靜置10分鐘,或用無菌紙巾輕壓吸收多餘水分。
實用建議
-
練習時可用無菌水代替菌液,觀察劃線軌跡是否流暢
-
每劃完一區就轉動培養皿30-45度,保持手臂姿勢固定
-
第四區最好只用到接種環的側邊緣,增加分離效果
-
遇到難劃的菌種(如黏液型菌落),可改用三角形劃線法
記住這些訣竅後,不妨拿廢棄培養基多練習幾次。熟練後你會發現,成功的四區劃線就像在培養皿上跳華爾滋,每個轉折都要優雅又精準!下次實驗前先把這篇筆記拿出來複習,保證能大幅提升成功率喔~
四區劃線法
四區劃線法是微生物實驗中常用的分離純化技術,透過在培養基上劃分四個區域,讓菌落能逐步稀釋分散。這個方法看似簡單,但很多新手常因細節沒注意而失敗,導致菌落長得太密集或分布不均。今天就來分享幾個實用技巧,讓你輕鬆掌握四區劃線法的精髓!
核心要點
-
角度與力道控制:劃線時接種環要與培養基保持30-45度角,力道要輕柔均勻。太用力會刮傷培養基,太輕則可能無法有效轉移菌液。
-
分區順序很重要:記得要從最密集的第一區開始,每劃完一區都要燒灼滅菌接種環,冷卻後再從前一區的尾端開始劃下一區。
-
菌液濃度關鍵:菌液太濃會導致菌落長成一片,建議先用生理鹽水適當稀釋。可以用接種環沾取菌液後,在試管壁輕輕刮掉多餘液體。
實用建議
-
培養前檢查:劃完線後先對光檢查,確認四區線條清晰分明、沒有交錯重疊。若發現劃線不理想,建議重來避免浪費時間。
-
環境控制:操作時盡量在無風環境進行,避免空氣流動影響劃線品質。實驗前用酒精擦拭工作台面,減少污染機會。
-
練習小技巧:新手可以先在廢棄培養基上練習劃線手感,熟悉後再正式操作。記得劃線速度不要太快,保持穩定節奏效果更好喔!
常見問題解答
為什麼我的四區劃線總是無法成功分離單一菌落?
這通常是因為劃線時力道不均或角度不對。建議新手練習時要輕柔且保持一致的壓力,劃線角度約30-45度最理想。另外,每劃完一區都要確實燒灼接種環,避免帶菌過多。記得最後一區要輕輕劃過前一區2-3次就好,太密集反而會影響分離效果。
四區劃線後菌落長太少怎麼辦?
可能是接種量不足或培養基太乾。建議先用接種環沾取較多菌液,在第一區塗佈時稍微用力些。另外檢查培養基是否新鮮,保存時要用封口膜密封避免水分蒸發。若環境太冷也會影響生長,可將培養皿倒置放在28-30°C環境培養。
如何避免四區劃線時交叉污染?
關鍵在於接種環的滅菌程序。每劃完一區後,要將接種環在火焰中燒至通紅,冷卻15-20秒再進行下一區。操作時培養皿蓋不要完全打開,維持45度角就好。建議在無風環境操作,避免空氣中的雜菌掉入。
為什麼我的第四區還是有很多菌落聚集?
這表示前三區的稀釋不夠充分。解決方法是第一區要確實塗佈均勻,第二、三區劃線時要減少與前一區的重疊範圍。也可以嘗試改用「Z字型」劃線法,每區劃線方向改變90度,能更有效分散菌落。
四區劃線最適合用哪種接種工具?
新手建議使用一次性塑膠接種環,比較好控制力道。進階者可用金屬接種環,但要注意燒灼後的冷卻時間。特殊菌種可分離時,可改用L型玻棒,但需要練習掌握旋轉技巧。記得無論用哪種工具,都要保持穩定且輕柔的劃線動作。
培養時間要多久才能觀察結果?
一般細菌在37°C培養18-24小時即可,但有些生長較慢的菌種可能需要48小時。黴菌類通常要培養3-5天。建議每天觀察一次,太早打開可能看不到明顯菌落,太晚則可能過度生長影響判斷。
四區劃線法適合所有微生物嗎?
不是每種微生物都適用。對於特別脆弱或生長緩慢的菌種,建議改用傾注平板法。厭氧菌也需要特殊處理。另外,若樣本中菌量極少時,直接塗佈法可能更適合。操作前最好先了解目標微生物的生長特性。